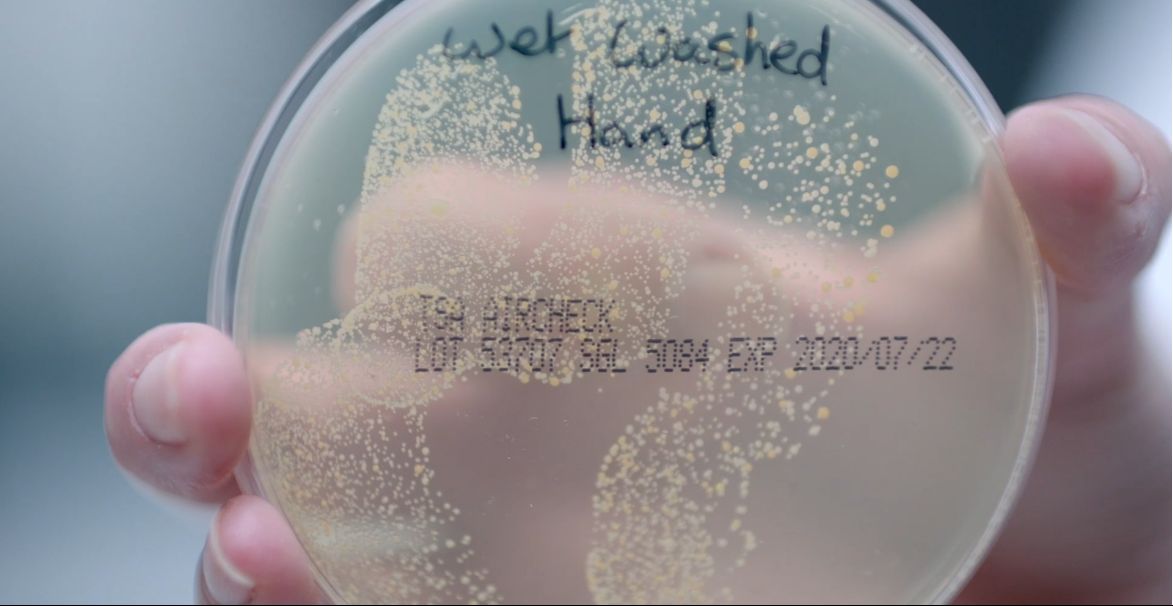
Hygiene des mains

Dyson Professional & le Groupe Hôtelier Evok, quand la performance rencontre l’expérience.
Dyson équipe les suites du groupe Hôtelier Evok (France) avec toute la gamme des technologies de soin capillaires : le sèche-cheveux Dyson Supersonic™, le Dyson Airwrap™ et le lisseur Dyson Corrale™.
-

-
Dyson & le Groupe Evok : un voyage expérientiel au cœur du luxe et de l’innovation.
Evok, groupe hôtelier français décline une identité singulière pour chaque établissement et s’inscrit dans une excellence du service. Chaque adresse à sa spécificité, son univers, son style de vie inspiré de son environnement.
Six établissements sont déjà équipés des technologies Dyson, permettant ainsi aux clients de profiter d’une expérience unique et personnalisée.
A Paris, le Nolinski est le dernier hôtel du groupe à avoir été équipé des sèche-cheveux Dyson Supersonic™. Au cœur de la capitale, le Sinner, la Cour des Vosges et le Brach bénéficient déjà des appareils de soin des cheveux Dyson.
Ce dernier s’est également équipé des derniers purificateurs d’air Dyson dans son club de sport.
“Le bien-être de nos hôtes et clients est essentiel. Offrir un air purifié et un environnement sain, notamment au Club de Sport, grâce aux purificateurs Dyson y contribue. Nos hôtes en suites et les membres du club de sport ont la possibilité d’utiliser un sèche-cheveux Dyson. Ils expérimentent ainsi le meilleur de la technologie Dyson sans chaleur extrême. Une offre que nous avons souhaité proposer à nos clients dans le but de leur faire vivre une expérience toujours plus insolite et confortable. ”, Solenn Gubri, directrice marketing et communication du groupe Evok.
-
Evok et Dyson, c’est avant tout une histoire qui se raconte autour de valeurs communes : la quête de l’excellence, l’expertise du design, couplé à la volonté de pousser l’innovation technologique à son paroxysme.
Avec la volonté de proposer une expérience toujours plus premium à ses clients, c’est tout naturellement que le groupe Evok s’est tourné vers Dyson pour équiper ses établissements avec les technologies Dyson.
« Au-delà du design, les solutions Dyson sont différenciantes des produits que nous pouvons trouver sur le marché. Ils garantissent une facilité d’utilisation et rendent l’expérience de nos clients unique et désirable. Pour nous, choisir Dyson comme partenaire privilégié était une évidence compte tenu de notre exigence et de notre positionnement luxe. », Solenn Gubri. -

Dyson Professional : Des technologies performantes au service des hôteliers.
Partout en France, 850 hôteliers font déjà confiance aux technologies Dyson Professional™.
Au cœur de prestigieux établissements tels que le Bristol ou l’Hôtel Hermitage à Monte Carlo, les clients peuvent profiter d’équipements performants tels que les sèche-mains Dyson Airblade™, les sèche-cheveux Dyson Supersonic™ ou encore les purificateurs d’air et ventilateurs Dyson.
La qualité et l’innovation des technologies Dyson sont les principaux critères de choix pour les hôteliers. Ils proposent ainsi l’environnement le plus sain et premium à leurs clients. L’expérience étant au cœur de leur ambition, ces hôtels redoublent d’efforts et s’entourent des meilleurs produits afin de permettre à chaque client de se sentir valorisé et comme à la maison.
"Ce qui nous intéresse, c'est de savoir si notre type de technologie peut faire une grande différence et si elle peut vraiment faire le travail beaucoup mieux que les produits existants." Sir James Dyson - Ingénieur et fondateur Dyson.
Équiper mon entreprise
Nos articles Newsroom à la une
Contact Presse
Email: [email protected]